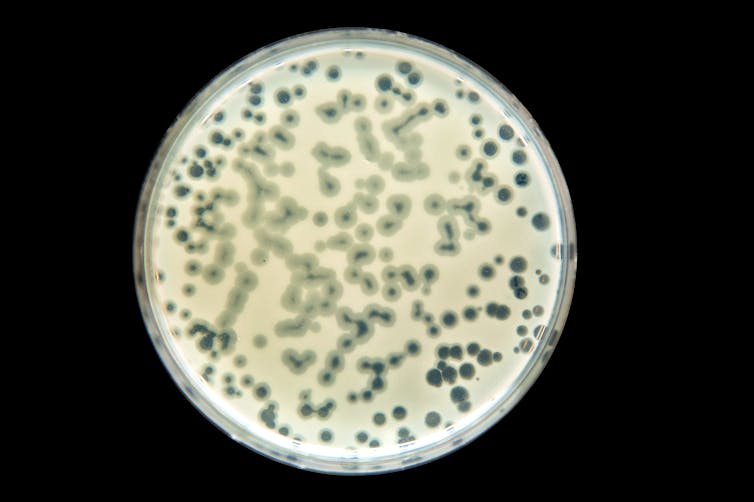

Antimicrobial resistance is one of the biggest global threats to health, food security and development. This month, The Conversation’s experts explore how we got here and the potential solutions.
As bacteria become resistant to antibiotics, more people will become infected and die of untreatable bacterial infections. By 2050, drug-resistant infections are predicted to kill ten million people a year.
So researchers are desperately seeking viable alternatives. One promising therapy uses specialised viruses called bacteriophages to invade and kill bacteria. They’re called “phages” for short.
This “phage therapy” has been used to treat antibiotic-resistant infections in small numbers of people who would have died without another way to kill the bacteria causing their infections.
But phage therapy is complicated, more complicated than prescribing antibiotics and picking up a script from the pharmacy.
Read more: The rise and fall of antibiotics. What would a post-antibiotic world look like?
What is phage therapy?
In the wake of COVID, we’re all familiar with viruses that infect human cells. There are also viruses that infect bacteria, known as phages.
Just as viruses that infect humans only affect certain types of human cells, phages prefer to infect certain types of bacteria. MS2 phage, for example, can infect Escherichia coli (E. coli) and some related bacteria – but not all of them.

Often, phages infect bacteria and just remain there, existing within the bacterium.
Sometimes, phages infect bacteria with lethal consequences for the infected bacterium. This is what can be harnessed and turned into phage therapy.
If the right phage can be found, it can be delivered to the infection site (either intravenously, topically to the skin or by aerosol inhalation), where it will find, infect and kill the bacteria causing the patient’s infection.
Read more: Viruses are both the villains and heroes of life as we know it
Since phages don’t infect and cause disease in humans, phage therapy selectively targets and kills the bacteria in the patient, and not the patient. An added bonus is phages leave other beneficial bacteria unaffected, unlike antibiotics.
So how is phage therapy prepared?
Before use, the right phage – capable of infecting the bacteria causing the infection – must be matched to target the infecting bacteria. This involves developing comprehensive phage libraries by isolating and selecting phages with the desired properties.
Fortunately, phages are everywhere – in soil, water, plants, animals and us. Finding and characterising them is straightforward, but takes time.
Successfully matching phage to the specific bacteria causing the patient’s infection requires lab technicians to isolate the bacteria first. This takes one to three days.

Then, the isolated bacterium is tested against hundreds of phages from the phage library to find one that can infect and kill that bacterium. The methods are slow, labour-intensive and take another few days.
Finally, when a phage that can kill the bacterium is identified, that specific phage, or a cocktail of multiple lethal phages, must be manufactured and administered to the patient.
Ironically, the unique advantages that make phage therapy a viable treatment for antibiotic-resistant infections bring challenges for treating lots of patients.
Testing for clinical efficacy is still under way
Before phage therapy can be approved for widespread use, it must meet the stringent safety and efficacy requirements. Efforts to achieve this for specific infections are currently underway in academic and commercial research settings.
In the meantime, phage therapy is available in the United States on an ad hoc basis for “compassionate use”. In Australia, a “special access scheme” provides limited access, with efforts to expand access underway.
Read more: Do you think you have a penicillin allergy? You might be wrong
Individual instances of phage therapy have saved the lives of those who would otherwise have died. But while there is a growing body of research supporting the efficacy of phage therapy, well-designed clinical trials are needed to establish its effectiveness.
Manufacturing presents a number of challenges
Phages are biological products that require careful production and quality-control processes. Propagating phages in the lab is one thing, but preparing them to a standard that can be applied, ingested, instilled or even injected into patients is another.
Developing scalable and standardised methods for phage production, purification and formulation is essential to meet the demand for widespread use.
Phages are made up of DNA or RNA, protein, and sometimes fats (known as lipids), all of which can be compromised if exposed to unfavourable conditions.
Pharmaceutical preparations of phage need to be transported, stored and dispensed in ways that preserve their biological activity, which can vary tremendously.
Bacteria can become phage-resistant
Similar to antibiotics, bacteria can develop resistance to phages over time. This can occur through various mechanisms, such as the modification of bacterial surface receptors targeted by phages to gain entry to the bacteria.
Ways to minimise or overcome the development of resistance need to be explored to ensure long-term effectiveness. This includes using phage cocktails, staggered administration of single phages or combining phage therapy with other treatments.
Commercial viability
Antibiotics aren’t “one size fits all” for bacterial infections, but one antibiotic covers many infections and many different bacteria. Prescribing antibiotics takes moments, treatment can start right away, and they have a large and established industrial, commercial and regulatory framework surrounding them.
In contrast, the customisation involved in delivering phage therapy takes a lot of time, labour and resources. This could make phage therapy relatively expensive.
Read more: Could new antibiotic clovibactin beat superbugs? Or will it join the long list of failed drugs?
To prepare bespoke phage preparations on demand, there must be a commercially viable and sustainable pathway to set up and maintain the infrastructure needed.
Much of the technology already exists to modernise, standardise and massively scale the phage therapy pipeline. With continued dedication, collaboration and investment, we have the potential to harness phage therapy as a tool in the fight against drug-resistant infections.
Read the other articles in The Conversation’s series on the dangers of antibiotic resistance here.
Christine Carson receives funding from the WA Future Health Research and Innovation Fund, and the CUREator program, a national biotechnology incubator delivered by Brandon BioCatalyst. She has a commercial interest in companies developing diagnostic tests, and preventing viral infections.
Lucy Furfaro receives funding from the National Health and Medical Research Council (NHMRC) and is associated with Phage Australia.
This article was originally published on The Conversation. Read the original article.








